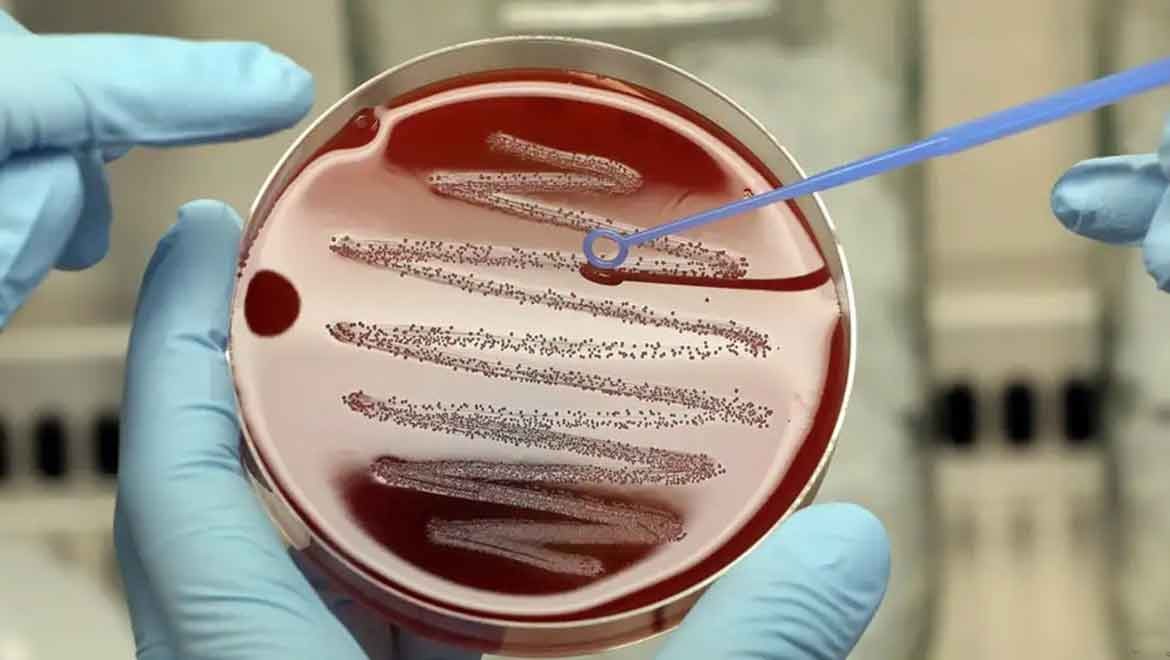
Dünyanın en tehlikeli sekiz bakterisi

Her yıl milyonlarca insan, bakteriyel enfeksiyonlar nedeniyle hayatını kaybediyor. Bu enfeksiyonlar, antibiyotiklerle tedavi edilse bile ölümler engellenemiyor. Çünkü birçok durumda, bakteriler ilaçlara karşı direnç kazanmış oluyor.
Dünya Sağlık Örgütü'nün (DSÖ) tahminlerine göre, bakteriyel antibiyotik direnci, 2019 yılında dünya genelinde 1,27 milyon kişinin doğrudan ölümüne yol açtı. Bu tür dirençlerle bağlantılı olabilecek ölümlerin toplam sayısının ise yaklaşık 5 milyonu bulduğu tahmin ediliyor.
Antibiyotik direnci ve antimikrobiyal direnç arasındaki fark
Bu yazı, bakterilerin antibiyotiklere karşı geliştirdiği dirence odaklanıyor. Buna karşın "antimikrobiyal direnç (AMR)" terimi, bakteriler, parazitler, virüsler ve mantarlar dahil olmak üzere, tüm mikropları kapsıyor. Bu mikroplar, yaygın tıbbi tedavilere karşı direnç geliştirebiliyor.
Buradaki temel sorun, mevcut ilaçların giderek daha az etkili veya tamamen etkisiz hale gelmesi, alternatiflerin ise genellikle bulunmaması. Bu nedenle, idrar yolu enfeksiyonları gibi kolayca tedavi edilebilecek hastalıklar bile bazen ölümcül olabiliyor.
Dünya Sağlık Örgütü'ne göre bakteriler nasıl sınıflandırılıyor?
Dünya Sağlık Örgütü (WHO), bakterileri çeşitli kriterlere göre sınıflandırıyor. Bu kriterler, ölüm oranları, enfeksiyon sıklığı, ölümcül olmayan sağlık yükü, direnç gelişimi, bulaşıcılık, önlenebilirlik, tedavi seçenekleri ve yeni ilaç geliştirme olarak sıralanıyor.
Bakteriler, her bir kriter için puanlanıyor ve ardından sıralamaya alınıyor. DSÖ'nün "2024 öncelikli patojenler" listesinde 24 bakteri bulunuyor.
İşte bunlar arasında en tehlikeli olan sekiz bakteri:
1. Klebsiella pneumoniae
· Kaynak: İnsan bağırsakları ve dışkılarında bulunur.
· Hastalıklar: Zatürre, kan zehirlenmesi, yara enfeksiyonları ve menenjit.
· Direnç: Karbapenemlere dirençli, bu da tedavi seçeneklerini sınırlar.
Klebsiella, bağırsaklarda ve insan dışkısında oluşan bir bakteri türü. Klebsiella pneumoniae zatürreye, kan zehirlenmesine ve yara enfeksiyonlarına neden olabiliyor. Bakteri, sinir sistemine girerse menenjite yol açabiliyor.
Hastanelerde Klebsiella pneumoniae, "süper mikrop" olarak adlandırılan bir bakteriye dönüşebilir. Süper mikroplar hızla yayılır ve çoklu dirençlidir. Çeşitli antibiyotiklerle yapılan tedaviler başarısız olur.
Klebsiella pneumoniae, aynı zamanda "yedek antibiyotik" adı verilen karbapenemlere karşı da dirençli. Bunlar, yalnızca diğer tüm tedaviler başarısız olduğunda kullanılıyor. Ancak bu antibiyotiklerin gelişigüzel kullanılması, direnç gelişimini teşvik ediyor.
2. Escherichia coli (E. coli)
· Kaynak: İnsan ve hayvan bağırsaklarında doğal olarak bulunur.
· Hastalıklar: İshal, idrar yolu enfeksiyonları, zatürre ve sepsis.
· Direnç: Üçüncü nesil sefalosporinlere ve karbapenemlere dirençli.
Klebsiella bakterileri gibi Escherichia coli (E. coli) bakterileri de genellikle insan ve hayvanların bağırsaklarında bulunuyor. Ancak çevrede, yiyeceklerde ve suda da bulunabiliyorlar.
E. coli türlerinin çoğu zararsız. Ancak bazıları ishal, idrar yolu enfeksiyonları, zatürre ve sepsis gibi hastalıklara neden olabilir. Paris'deki E. coli seviyeleri, Fransa'daki 2024 Yaz Olimpiyatları sırasında hararetli tartışmalara yol açmıştı.
E. coli, bel soğukluğu gibi cinsel yolla bulaşan enfeksiyonların tedavisinde de kullanılan ve yaygın olarak reçete edilen bir antibiyotik olan üçüncü kuşak sefalosporinlere karşı dirençli. E. coli ayrıca karbapenemlere karşı da direnç gösteriyor.
3. Acinetobacter baumannii
· Kaynak: Hastane enfeksiyonlarıyla bağlantılıdır.
· Hastalıklar: Kan zehirlenmesi, zatürre ve yara enfeksiyonları.
· Direnç: Karbapenemlere dirençli.
2012 yılında araştırmacılar Acinetobacter baumannii'yi, "hastane kaynaklı enfeksiyonlarla ilişkili ortaya çıkan fırsatçı bir bakteriyel patojen" olarak tanımlamıştı.
Hastaların hastanede kalma süresi uzadıkça enfeksiyon riski de artıyor. Bağışıklık sistemi zayıflamış kişiler özellikle risk altında oluyor. Acinetobacter baumannii de karbapeneme dirençli.
4. Mycobacterium tuberculosis
· Kaynak: Tüberkülozun (TB) etken maddesi.
· Hastalıklar: Tüberküloz
· Direnç: Rifampisin gibi ilaçlara direnç geliştirmiştir.
Mycobacterium tuberculosis (TB), akciğerlerde potansiyel olarak ölümcül bir bakteriyel enfeksiyon olan tüberküloza neden oluyor. Bu bakterinin bazı türleri çoklu dirençlidir. Bu da artık çeşitli ilaçlara yanıt vermedikleri anlamına gelir.
2023 yılında 161 bini HIV enfeksiyonlu olmak üzere, toplam 1,25 milyon kişi tüberkülozdan öldü.
Dünya Sağlık Örgütü, "Tüberküloz, üç yıl boyunca yerini koronavirüse (Covid-19) bıraktıktan sonra, yine dünyada tek bir bulaşıcı ajandan kaynaklanan ölümlerin önde gelen nedeni olacak" açıklamasını yaptı.
Mycobacterium tuberculosis, tüberküloz ve cüzzam gibi enfeksiyonları tedavi etmek için kullanılan bir antibiyotik olan rifampisine dirençli.
5. Salmonella Typhi
· Kaynak: Tifo hastalığına neden olur.
· Hastalıklar: Ateş ve enfeksiyonlar.
· Direnç: Florokinolonlara dirençlidir.
Salmonella Typhi, yüksek ateşle karakterize, yaşamı tehdit eden bir hastalık olan tifo ateşine neden oluyor. Özellikle Asya, Afrika ve Latin Amerika'nın bazı bölgeleri gibi temiz su kaynaklarının sınırlı, hijyenin yetersiz, kirli su ve gıdanın bulunduğu bölgelerde yaşayan insanları etkiliyor.
ABD Hastalık Kontrol ve Önleme Merkezlerinin (CDC) tahminlerine göre, dünya çapında her yıl yaklaşık 9 milyon kişi tifoya yakalanıyor. Salmonella Typhi, çok sayıda yan etkisi olan geniş spektrumlu bir antibiyotik olan florokinolon'a dirençli. Avrupa İlaç Ajansı (EMA), bu nedenle florokinolon kullanımının kısıtlanmasına karar verdi.
6. Shigella Türleri
· Kaynak: Kirli gıda ve su yoluyla bulaşır.
· Hastalıklar: İshal, karın ağrısı ve ateş.
· Direnç: Florokinolonlara dirençlidir.
Shigella'nın dört türü vardır: Shigella sonnei, Shigella flexneri, Shigella boydii ve Shigelladysenteriae. Shigella bakterileri ishale, karın ağrısına ve ateşe neden oluyor.
Kirlenmiş yiyecek ve su yoluyla yayılıyor, ayrıca cinsel yolla da bulaşıyorlar. Shigella, florokinolonlara da dirençli.
7. Enterococcus faecium
· Kaynak: Bağırsak florasında bulunur.
· Hastalıklar: İdrar yolu enfeksiyonları ve sinir sistemi enfeksiyonları.
· Direnç: Vankomisine dirençlidir.
Enterococcus faecium, "mikrobiyom" olarak da bilinen bağırsak florasında yaşar. Bakteriler diyabet veya kronik böbrek hastalığı olan kişilerde ciddi hastalıklara neden olabilir.
Enterokoklar, vücudun bağırsakların dışındaki kısımlarına girerlerse idrar yolu enfeksiyonlarına ve sinir sistemi enfeksiyonlarına neden olabilirler.
Enterokoklar, stafilokokların neden olduğu enfeksiyonları tedavi etmek için de kullanılan bir antibiyotik olan vankomisine dirençli. Stafilokoklar da birçok antibiyotiğe karşı direnç gösteriyor.
8. Pseudomonas aeruginosa
· Kaynak: Ameliyat sonrası enfeksiyonlara neden olur.
· Hastalıklar: Kan, akciğer ve idrar yolu enfeksiyonları.
· Direnç: Karbapenemlere dirençlidir.
Pseudomonas aeruginosa, genellikle hastanelerde yapılan ameliyatlardan sonra kanda, akciğerlerde, idrar yollarında ve vücudun diğer kısımlarında enfeksiyonlara neden oluyor. Hastalık veya ilaç nedeniyle bağışıklık sistemi zayıflamış kişiler özellikle risk altında.
Pseudomonas aeruginosa, bakterileri karbapenemler de dahil olmak üzere çoklu dirençli.